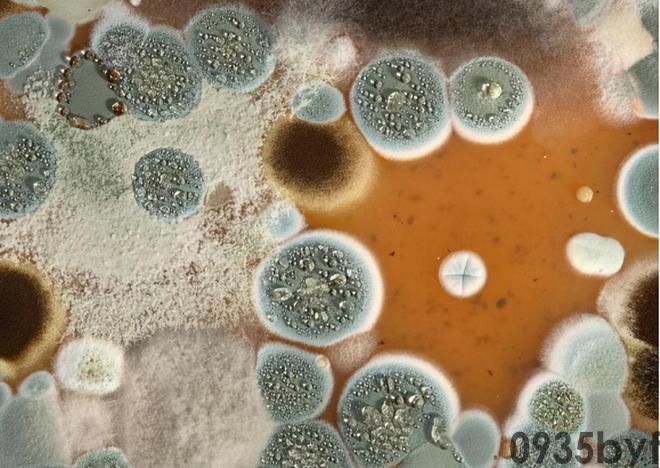
我国脚气患者过亿“祸根”被揪出:这些东西是脚气最大的帮凶(图2) 我国脚气患者过亿“祸根”被揪出:这些东西是脚气最大的帮凶(图2)

脚气病在不同人身上呈现的方式都不一样,有些人是脚臭、有些人是脚痒、有些人是红肿、有些人是大面积的起皮掉皮。

知道脚气病是什么东西以及会引起怎样的症状之后,我们更加要注意的是病因以及引起病因的“祸根”。
中医认为,脚气的病因有多种,湿热下注、脾虚湿盛、气血凝滞、血瘀气滞以及肝肾阴虚等都会引起脚气。

肝肾阴虚则会让身体的精血无法滋养脚底的皮肤,皮肤屏障减弱就会让湿邪更加容易入体最终淤积于脚底引发脚气。
在外用药上的使用有抗真菌药膏,如硝酸咪康唑、酮康唑、特比萘芬等,这些药物能有效抑制或杀灭真菌,缓解脚气症状。
在口服药上的使用有酮康唑、氯霉素、特比萘芬、伊曲康唑、氟康唑等,适用于较为严重的真菌感染或外用药物疗效不佳的情况。
我们应该及时清洗换下来的袜子以及及时晾晒干,鞋子如果不适合清洗也要注意保持干燥,可以选择有太阳的时候拿出去晒。
在外面的时候切忌光脚,去别人家做客的时候需要脱鞋就不要为了图舒服把袜子脱下来,尽量和着袜子穿拖鞋。

比如夏天玩水的游泳池、水上乐园,健身房的室、淋浴间,北方的公共澡堂以及放松的店以及足浴店等。

泳池不可能说百分百将这些用品上的真菌细菌消杀干净,这就导致很容易在游泳池以及水上乐园的用品上沾染到导致脚气的真菌。

承先生的女儿在这里玩水后第二天就发了40多度的高烧,据承先生反馈,医院说可能是水质不干净引起的细菌感染。

而且在这种地方清洗身体、换衣服的时候切忌不要用公用的贴身用品,最好这些毛巾之类的用自己从家里带一次性的用品。

北方素有搓澡的习惯,所以北方的公共澡堂以及南北都有的足浴店,都会让自己的双脚接触到很多共用的东西。

北方搓澡师傅的搓澡巾、足浴店的泡脚桶,这些甚至比游泳池以及水上乐园的公用物品以及水体更加危险。
对于我们平时习惯去的公共场合我们反而更加不能掉以轻心,不然明明是高兴去玩去放松,结果回来后染一身脏病。


脚气病多发于中老年人的原因在于中老年人皮肤代谢能力相对较差,这导致中老年人长期脚底多汗潮湿。
而男性比女性更加容易得脚气的原因则是因为男性的脚部汗腺比女性的发达很多,加上不讲究的生活习惯。


大家在了解脚气病是什么东西、发病病因以及引起病因的“祸根”之后,又有什么比较好的预防方法呢?
《推荐你使用脚气克星(布医坊水杨酸抑菌粉)布医坊指定加盟商,实体店内180一盒,拼多多大促销,正品保证,假一赔十》